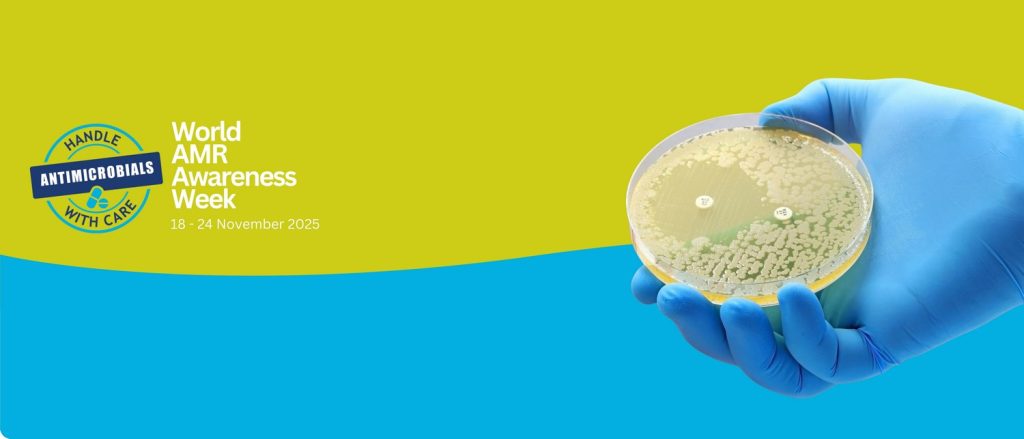
مقاومت ضدمیکروبی (AMR) چیست و چگونه گسترش می یابد؟

مقاومت ضدمیکروبی (AMR) چیست و چگونه گسترش می یابد؟
عوامل ضد میکروبی موادی هستند که رشد میکروارگانیسمها را متوقف میکنند و جهت پیشگیری و درمان بیماریهای عفونی در انسان و حیوانات استفاده میشوند. این دسته مواد بر اساس نوع ارگانیسم هدفشان تقسیمبندی میشوند و شامل آنتیبیوتیکها، ضد ویروسها، ضد قارچها و ضد انگلها میباشند. تعریف مقاومت میکروبی مقاومت ضدمیکروبی (Antimicrobial Resistance) یکی از چالشهای …